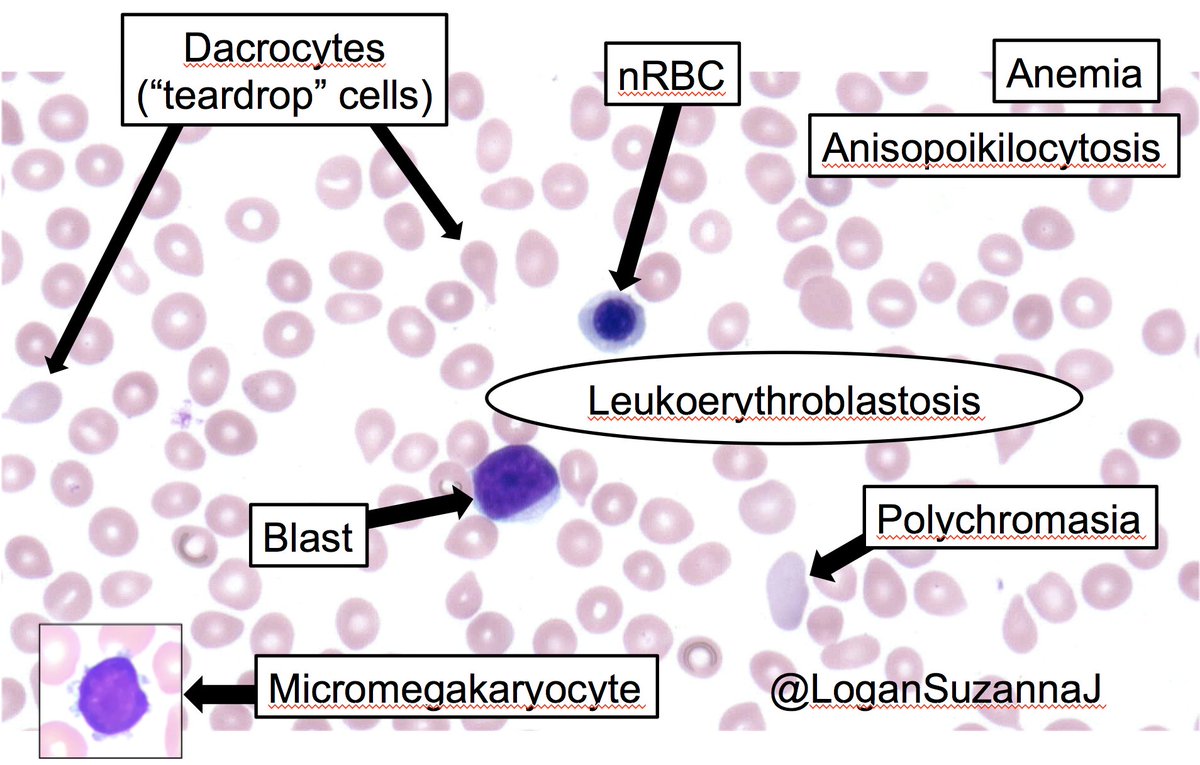
Leukoerythroblastosis and myelophthisic anemia can be associated with any marrow-replacing process. In this case, the likely etiology was post-essential thrombocythemia myelofibrosis.

Marianne Beynon, MD
@beynonmd
2018-19 Forensic Pathology Fellow
ID: 708770857108115456
https://www.bcm.edu/departments/pathology-and-immunology 12-03-2016 21:45:15
850 Tweet
1,1K Followers
460 Following

If Pacinian “neuroma” is a real thing, then this is the closest I’ve ever seen to a convincing example! If one Pacinian corpuscle is amazing, why not a whole cluster of them?! Gorgeous pic from Vishwas Parekh, MD! #dermpath #Pathology #dermatology #bstpath



#Pathology of toxoplasmosis, a YouTube video that includes images from tweets posted by Marianne Beynon, MD Sylvain Trahan MD @DrFNA Andrew Gao Vicki Jeffers Internal medicine Sandro Casavilca-Zambrano Melissa M. Blessing and the #yalerosenslidecollection Thank you all! youtu.be/63tiFHOzYb8 #neuropath #toxoplasmosis




Four years come and go quickly and we say farewell once again to another graduating class. #FutureIsBright BCMHouston Texas Society of Pathologists #Pathology




Great tips Jennifer Waljee Vineet Chopra Sanjay Saint for mentoring millenials from JAMA jamanetwork.com/journals/jama/… #meded @DrSMBean





Spotter! 28/M ? anal polyp. #pathology #pathboards #dermpath Silvija Gottesman MD Bin Xu Dr. Suraksha.Rao B Sol Belingeri Kalyani Bambal 𝗗𝗿 𝗔𝗵𝗺𝗲𝗱 𝗞𝗮𝗹𝗲𝗯𝗶, 𝕆𝔾𝕎 @CArnold_GI Sanjay Mukhopadhyay Luis Humberto Cruz C Jerad Gardner, MD Gerônimo Jr. Karen Pinto DNB, FRCPath Thejas K Murthy @luis_munozf Woo Cheal Cho, MD Pembe Oltulu, MD Srinivas Rao




Disseminated histoplasmosis #pathbugs #crittersontwitter Probably my most retweeted post ever. If I hadn't posted it on Twitter, this pic would be sitting somewhere unused, bereft of educational value ClevelandClinicLabs I Heart Pathology @youngasklepios x.com/smlungpathguy/…

Today an #Autopsy case with surprise. 60 yo male. Chronic liver and pancreatic disease related to enolic habit. Autopsy finding in the kidney. Differential diagnosis? Marypoppins Laura G. Pastrián MD Bin Xu Zubair Baloch #GUPath #SurgPath #RenalPath #Pathology


Rosai-Dorfman disease - sinus histiocytosis with massive lymphadenopathy. Rare, usually good prognosis, most commonly presents as cervical lymphadenopathy, Sheets of histiocytes, some with emperipolesis SHML cells CD68+ PS100+ Juan Rosai #pathology #HemePath #PediPath